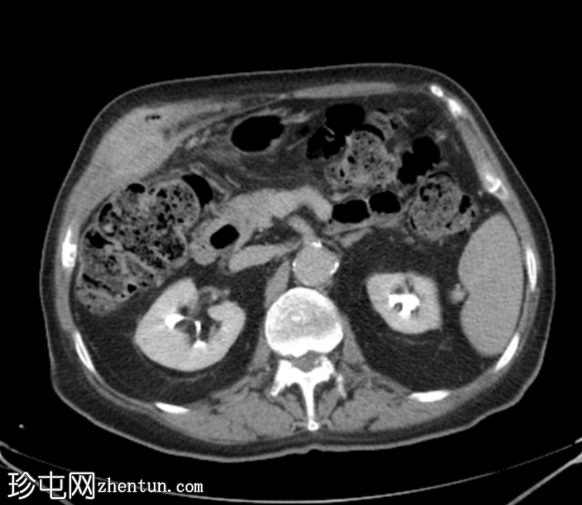
5.png

临床表现
右侧下丘脑疼痛,持续1个月。
患者资料
年龄:80岁
性别:男
CT

轴位
平扫

轴位增强扫描
动脉期

轴位增强扫描
门静脉期

轴位增强扫描
门静脉期
轴位增强扫描
延迟期

冠状位增强扫描
门静脉期

矢状位增强扫描
门静脉期
胆囊底部可见一枚较大的(3厘米)高密度结石,胆囊壁增厚并强化,主要位于胆囊底部。胆囊壁可见一小穿孔,感染扩散至胆囊外,并在肝下区可见气体腔。感染进一步扩散至腹壁肌肉,腹壁肌肉内可见脓肿,边缘强化明显,囊性坏死中心,腔内可见气体腔。十二指肠第一段与炎症胆囊粘连。
检查结果提示急性胆囊炎合并腹壁脓肿。
右侧膀胱有两个小憩室。
患者接受了紧急手术,术中发现急性胆囊炎,并发胆囊壁穿孔、胆囊十二指肠瘘和前腹壁脓肿形成。
行开放式胆囊切除术、脓肿切除术和十二指肠壁修补术。
胆囊、大结石和前腹壁脓肿标本送病理检查。
病理报告
临床诊断:胆囊穿孔合并前腹壁脓肿形成。
标本类型:开放式胆囊切除术标本及部分脓肿壁活检标本。
肉眼观察:收到的胆囊组织呈多块碎片状,总大小为 7 x 7 厘米,内壁呈碎片状,切面光滑,并伴有一颗 3.0 厘米的硬结石。另有一块独立的脂肪组织,大小为 6 x 4 x 2 厘米,切面呈分叶状,质地柔软,呈棕褐色。
显微镜下观察:对收到的标本进行切片检查,发现胆囊黏膜部分溃疡,黏膜下层可见急性炎症细胞浸润。胆囊壁可见化脓灶,伴有多形核白细胞增多和腹膜炎。
可见一处穿孔,可见明显的炎症反应和脓毒性肉芽组织。
可见一个反应性淋巴结。
可见一块独立的充血脂肪组织。
所检查的切片未见恶性肿瘤证据。
诊断:
行开放式胆囊切除术及部分腹壁脓肿活检;急性化脓性结石性胆囊炎伴穿孔和腹膜炎。一个反应性淋巴结肿大。一个独立的充血性脂肪组织。
病例讨论
患者接受了紧急胆囊切除术,同时切除了腹壁脓肿并修补了十二指肠壁。术后在重症监护室(ICU)观察一周,恢复顺利。
急性胆囊炎伴腹壁脓肿是一种罕见且严重的并发症,通常由胆囊穿孔引起,感染扩散至腹壁,形成局部脓肿,若不及时治疗,可能继发胆囊皮肤瘘。
如本例所示,这种并发症在老年男性中更为常见,通常发生于诊断延迟、病情被忽视的病例中。 |